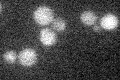
YBR201W
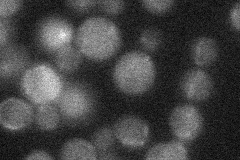
YBR201W

View description
Endoplasmic reticulum membrane protein, required for ER-associated protein degradation of misfolded or unassembled proteins; N- and C- termini protrude into the cytoplasm, has similarity to Dfm1p
Localization:
Intensity:
Fold change:
Significance:
-
C’ GFP library in SD
below threshold16.5 -
N' NOP1pr-GFP in SD

below threshold19.8227 -
N' TEF2pr-mCherry in SD

below threshold4.66838 -
N' NATIVEpr-GFP in SD
below threshold19.5335 -
N' TEF2pr-VC and Cyto-VN in SD

#N/A0 -
C’ GFP library in SD+DTT

cytosol19.171.16No -
C’ GFP library in SD+H2O2

cytosol14.120.85No -
C’ GFP library in Starvation Media

cytosol19.61.18No -
C’ GFP library on the background of Pup2-DaMP

below threshold -
C’ GFP library on the background of CCT mutant

below threshold16.69731.01169No
